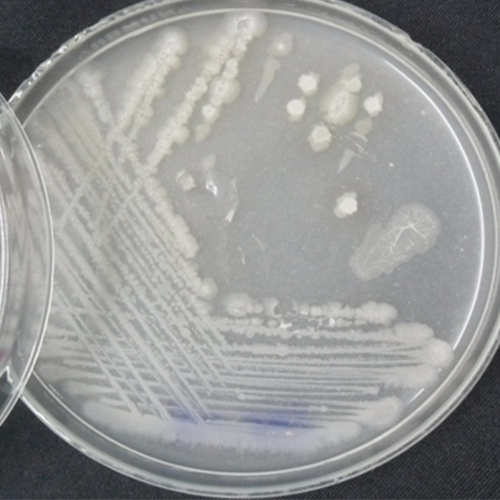

ข้อมูลวิชาการ
เกษตรอินทรีย์ (organic farming) เป็นเกษตรกรรมแบบหนึ่งซึ่งอาศัยเทคนิคอย่างการปลูกพืชหมุนเวียน ปุ๋ยพืชสด ปุ๋ยคอก และการควบคุมสัตว์รังควานทางชีวภาพ เกษตรอินทรีย์ใช้ปุ๋ยและสารฆ่าศัตรูพืชและสัตว์ (มีสารฆ่าวัชพืช ยาฆ่าแมลงและสารฆ่าเชื้อรา) หากถือว่ามาจากธรรมชาติ (เช่น กระดูกป่นจากสัตว์หรือไพรีทรินจากดอกไม้) แต่ไม่ใช้หรือจำกัดการใช้อย่างยิ่งซึ่งวิธีการต่าง ๆ (รวมปุ๋ยและสารฆ่าศัตรูพืชและสัตว์ปิโตรเคมีสังเคราะห์ ตัวเร่งการเติบโตของพืช เช่น ฮอร์โมน การใช้ยาปฏิชีวนะในปศุสัตว์ สิ่งมีชีวิตดัดแปรพันธุกรรม กากสิ่งปฏิกูลของมนุษย์ และวัสดุนาโน) โดยแสวงเป้าหมายซึ่งมีความยั่งยืน ความเปิดเผย การไม่พึ่งพา สุขภาพและความปลอดภัย
วิธีการเกษตรอินทรีย์มีการกำกับระหว่างประเทศและหลายประเทศบังคับใช้กฎหมาย โดยยึดมาตรฐานที่สหพันธ์ขบวนการเกษตรอินทรีย์ระหว่างประเทศ (IFOAM) ตั้งขึ้นเป็นหลัก IFOAM เป็นองค์การครอบคลุมระหว่างประเทศขององค์การเกษตรอินทรีย์ที่ตั้งในปี 2515
เกษตรอินทรีย์ ใช้หลักการสร้างความหลากหลายทางชีวภาพในระบบนิเวศเกษตรให้เกิดการผสมผสานเกื้อกูลซึ่งกันและกันอย่างเป็นองค์รวม มีการหมุนเวียนใช้ทรัพยากรในไร่นาให้เกิดประโยชน์สูงสุดหลีกเลี่ยงการใช้ปัจจัยการผลิตจากภายนอกระบบนิเวศเกษตร (ยกเว้นกรณีจำเป็น) ใช้ปัจจัยการผลิตที่เป็นชีวภัณฑ์ และสารอินทรีย์ที่ได้จากสิ่งมีชีวิต รวมทั้งสารอินทรีย์ที่เกิดขึ้นตามธรรมชาติ ปฏิเสธการใช้ปัจจัยที่เป็นสารเคมีสังเคราะห์รวมทั้งพันธุ์ที่ผ่านการปรับเปลี่ยนทางพันธุกรรม (GMO=Genetic Modified Organisms) โดยปัจจัยการผลิตเกษตรอินทรีย์ ใช้หลักการ ดังนี้
1. ใช้หลักและแนวคิดการเกษตรแบบองค์รวม ในระบบนิเวศเกษตรที่มี พืช สัตว์ ประมง ป่าไม้ ดิน น้ำ สังคมและเศรษฐกิจ ที่มีปฏิสัมพันธ์เชื่อมโยงซึ่งกันและกันอย่างมีบูรณาการโดยให้ความสำคัญของภูมิปัญญาท้องถิ่นผสมผสานกับเทคโนโลยีทันสมัย
2. เน้นการผสมผสานให้เกิดความหลากหลายเกื้อกูลซึ่งกันและกันระหว่าง พืช สัตว์ ประมง ป่าไม้ ในระบบไร่นาสวนผสมวนเกษตร และเกษตรทฤษฏีใหม่ตามแนวพระราชดำริ
3. ใช้พันธุ์ที่คัดเลือกให้เหมาะสมกับสภาพท้องถิ่นที่แตกต่างกันปฏิเสธการใช้พันธุ์ที่มีการตัดต่อทางพันธุกรรม (GMO)
4. เน้นการใช้ปัจจัยการผลิตที่เกิดจากการหมุนเวียนใช้ทรัพยากร ที่มีอยู่ในฟาร์มและในท้องถิ่นให้เกิดประโยชน์สูงสุดรวมทั้งเน้นการใช้เทคโนโลยีชีวภาพ ซึ่งได้ผลผลิตที่ปลอดภัยต่อผู้บริโภคและลดต้นทุนการผลิต
5. เน้นการใช้แรงงานคน สัตว์ และเครื่องทุ่นแรงขนาดเล็กที่ประหยัดพลังงานรวมทั้งการใช้หลักการธรรมชาติในการจัดการศัตรูพืช การปรับปรุงดิน ฯลฯ เพื่อลดต้นทุนการผลิตและอนุรักษ์ทรัพยากรธรรมชาติและสิ่งแวดล้อม
6. มีเป้าหมายการผลิตเพื่อความปลอดภัยต่อผู้ผลิตและผู้บริโภค การรักษาสิ่งแวดล้อม และความยั่งยืน


ปุ๋ยอินทรีย์ (Organic Fertilizer) หรือ ปุ๋ยหมัก (Compost) คือ ปุ๋ยที่ได้จากการย่อยสลายอินทรีย์วัตถุทางชีวเคมีโดยจุลินทรีย์กลุ่มใช้ออกซิเจน (Aerobic Microorganisms) จนเป็นประโยชน์ต่อพืช
ปุ๋ยอินทรีย์ เป็นปุ๋ยทำจากวัสดุอินทรีย์ มีธาตุอาหารที่เป็นประโยชน์สำหรับการเจริญเติบโตของพืช ผลิตจากวัสดุอินทรีย์ ของเสียจากโรงงาน(บางประเภท) มูลวัว มูลไก่ มูลค้างคาว ซากต้นไม้ ใบไม้ กรดอะมิโน โดโลไมท์ และแร่ธาตุต่าง ๆ นำมาบด เติมจุลินทรีย์ บ่มหมัก กลับกอง จนย่อยสลายกลายเป็นปุ๋ย โดยปุ๋ยอินทรีย์ มีลักษณะทางกายภาพได้หลายแบบ เช่น ปุ๋ยเม็ด ปุ๋ยผง และปุ๋ยน้ำ แต่ที่นิยมจำหน่ายในท้องตลาดส่วนใหญ่เป็นปุ๋ยเม็ด เนื่องจากสะดวกกับเกษตรกรในการนำไปใช้ ทั้งจากการหว่านด้วยมือ หรือใช้กับเครื่องพ่นเม็ดปุ๋ย
ข้อเด่น
ปุ๋ยอินทรีย์ที่เหนือกว่าปุ๋ยเคมี คือ ปุ๋ยอินทรีย์มีอินทรีย์วัตถุ มีธาตุอาหารรอง และจุลธาตุที่จำเป็นต่อจุลินทรีย์ดินและพืช ที่ปุ๋ยเคมีไม่มี นอกจากนี้ การใช้ปุ๋ยอินทรีย์ยังทำให้ดินมีสภาพเป็นกลาง ในขณะที่การใช้ปุ๋ยเคมีอย่างยาวนานจะทำให้ดินมีสภาพเป็นกรดซึ่งมีผลทำให้มีการละลายแร่ธาตุที่ไม่พึงประสงค์ออกมาให้แก่รากพืช เช่น อะลูมิเนียม ทำให้พืชมีลักษณะแคระแกร็นและเป็นโรคง่าย ปุ๋ยอินทรีย์ยังเพิ่มจำนวนจุลอินทรีย์ที่เป็นประโยชน์ และสิ่งมีชีวิตตามธรรมชาติ ทำให้ดินมีโครงสร้างโปร่ง ร่วนซุย อ่อนนุ่มอุ้มน้ำ
ข้อด้อย
ปุ๋ยอินทรีย์ คือ มีธาตุอาหารหลักต่ำกว่าปุ๋ยเคมี และต่ำกว่าปุ๋ยอินทรีย์เคมี ซึ่งผลิตจากการผสมปุ๋ยอินทรีย์และปุ๋ยเคมีเข้าด้วยกัน ทำให้บางครั้งต้องใช้ในปริมาณมากเพื่อให้ได้ปริมาณธาตุอาหารเพียงพอต่อความต้องการของพืช


ปุ๋ยที่ได้จากการนำจุลินทรีย์ที่มีชีวิต มีความสามารถในการสร้างธาตุอาหาร หรือช่วยให้ธาตุอาหารที่เป็นประโยชน์กับพืช มาใช้ในการปรับปรุงบำรุงดิน ทางชีวภาพ , กายภาพ หรือชีวเคมี ยังรวมถึงหัวเชื้อจุลินทรีย์อีกด้วย สรุป คือ ปุ๋ยชีวภาพมีหน้าที่ปลดปล่อยธาตุอาหารให้พืช ช่วยสร้างอาหารให้พืช แต่ไม่มีธาตุอาหารในตัวมันเอง เมื่อปลดปล่อยธาตุอาหารออกมาให้พืชได้ ปริมาณการใช้ปุ๋ยเคมีจึงลดลงประหยัดมากขึ้น เพราะการปลดปล่อยของมันจะออกมาในรูปที่พืชนำไปใช้ได้นั่นคือเคมี
ชนิดของปุ๋ยชีวภาพ มีดังนี้
•ไรโซเบียม
•อะโซโตแบคเตอร์
•สาหร่ายสีเขียวแกมน้ำเงิน
•แหนแดง
•เชื้อราไมคอร์ไรซ่า




จุลินทรีย์ ที่ใช้ป้องกันกําจัดศัตรูพืช สารชีวินทรีย์ หรือสารชีวภัณฑ์ เป็นการใช้รา แบคทีเรีย ไวรัส โปรโตซัวไส้เดือนฝอย และแมลงศัตรูพืชธรรมชาติ เป็นสารป้องกัน ควบคุมและกําจัดโรคและแมลงศัตรูพืชต่างๆ เพื่อลดหรือทดแทนสารเคมีป้องกนกำจัดศัตรูพืช
ปัจจุบันมีการนำจุลินทรีย์มาใช้ในการเกษตร โดยเฉพาะใช้ในการแปรรูปผลผลิต การผลิตอาหาร การปรับปรุงบำรุงดิน การป้องกันกำจัดโรค และศัตรูพืช และมีการพัฒนาการใช้จุลินทรีย์ในการเกษตรมากขึ้น ซึ่งแบ่งประเภทของจุลินทรีย์ได้เป็น 5 ประเภทคือ
1. ประเภทที่ใช้ในการผลิตอาหาร เช่น เห็ดชนิดต่างๆ
2. ประเภทที่ใช้ในการแปรรูปผลผลิต เช่น ยีส เชื้อรา ฯลฯ
3. ประเภทที่ใช้ในการปรับปรุงดิน เช่น ไรโซเบียม ไมโครไรซ่า ฯลฯ
4. ไวรัส
5. แบคทีเรีย
ข้อดี ปลอดภัยกับเกษตรกรผู้ใช้ และผู้บริโภค ไม่มีสารตกค้าง จุลินทรีย์มีความจำเพาะเจาะจงสูง เช่น เชื้อแบคทีเรียกำจัดแมลงจะเป็นอันตรายกับแมลงเป้าหมายบางชนิดเท่านั้น
ข้อด้อย ให้ผลช้าไม่รวดเร็วเท่าเคมี กำจัดศัตรูพืชได้เฉพาะเจาะจงไม่หลากหลาย จุลินทรีย์เป็นสิ่งมีชีวิตจึงอ่อนไหวต่อปัจจัยภายนอก เช่น แสงแดด อุณหภูมิ ความชื้น เป็นต้น
1.เชื้อแบคทีเรีย บาซิลัสทูริงเจรซิส(BT) ใช้กำจัดหนอนพวกหนอนต่างๆ หนอนกระทู้หอม หนอนกระทู้ผัก หนอนใยผัก
2.เชื้อรา ไตรโคเดอร์มา ป้องกันกำจัด โรครากเน่า โรคโคนเน่าผลเน่า โรคเหี่ยว โรคเน่าระดับดิน โรคกุ้งแห้ง
3 เชื้อรา บิวเวอร์เรีย ป้องกันกำจัด เพลี้ยกระโดดสีน้ำตาล เพลี้ยจักจั่น เพลี้ยไฟ เพลี้ยแป้ง บั่ว หนอนห่อใบ เพลี้ยอ่อน ไรขาว แมลงหวี่ขาว แมลงค่อมทอง ไรแดง
4. .เชื้อแบคทีเรีย บาซิลลัส ซับทีลิส ( BS) ป้องกันกำจัดเชื้อรา และแบคทีเรียหลายชนิด เช่น โรคแอนแทรกโนส โรคใบจุด โรคใบติด โรคใบไหม้ โรคแคงเกอร์
5.เชื้อรา เมทาไรเซียม ด้วงแรดมะพร้าว ด้วงหนวดยาว แมลงนุนหลวง แมลงดำหนามมะพร้าว เพลี้ยกระโดดสีน้ำตาล เพลี้ยจักจั่น เพลี้ยต่างๆ หนอนห่อใบข้าว
ข้อเสนอแนะ การใช้จุลินทรีย์ป้องกันกำจัดศัตรูพืชเป็นอีกทางเลือกหนึ่งที่ปลอดภัย แต่ด้วยข้อจำกัดด้านความจำเพาะจงเจาะศัตรูพืช การใช้ในการป้องกันหรือใช้เมื่อพบศัตรูพืชในระยะเริ่มต้น(ยังไม่ระบาด)ย่อมได้ผลที่มีประสิทธิภาพมากกว่า

ฮอร์โมนพืช เป็นสารเคมีภายในพืชซึ่งเกี่ยวข้องกับการเจริญของพืชไม่เพียงแต่การเจริญของพืชทั้งต้นเท่านั้น หากแต่ยังเกี่ยวข้องกับการเจริญของพืชแต่ละส่วนด้วย ในปัจจุบันทราบกันดีแล้วว่าฮอร์โมนพืชมีทั้งชนิดที่กระตุ้นการเจริญเติบโต และระงับการเจริญเติบโต ฮอร์โมนพืชที่พบในปัจจุบันคือออกซิน (Auxin) จิบเบอเรลลิน (Gibberellins) ไซโตไคนิน(Cytokinins) กรดแอบซิสิค (Abscisic Acid) หรือ ABA และ เอทธิลีน (Ethylene) ซึ่งมีสภาพเป็นก๊าซ
สารควบคุมการเจริญเติบโต (Plant Growth Regulator) เป็นสารเคมีที่สำคัญในการเกษตร เป็นสารอินทรีย์ซึ่งมนุษย์สังเคราะห์ขึ้นมาได้ ซึ่งบางชนิดมีคุณสมบัติเหมือนฮอร์โมนพืช มนุษย์รู้จักการใช้สารควบคุมการเจริญเติบโตมานานแล้ว เช่น กระตุ้นให้มะม่วงหรือสับปะรดออกดอกโดยการจุดไฟข้างสวน เพื่อให้เกิดควันซึ่งมีเอทธิลีนปนอยู่ สามารถกระตุ้นให้เกิดการออกดอกได้
โดยสารสกัดอินทรีย์ที่สกัดขึ้นมาอุดมไปด้วยธาตุอาหารและฮอร์โมนที่จำเป็นต่อการเจริญเติบโตของพืช จนได้สารออกฤทธิ์ทางชีวภาพ (Bio-Active compound) ที่พืชสามารถนำไปใช้ได้ทันทีอย่างมีประสิทธิภาพ
คุณประโยชน์
1.ช่วยเร่งการเจริญเติบโต ทำให้พืชโตเร็ว ต้นแข็งแรง
2.เร่งการฟื้นตัวของพืชหลังการเก็บเกี่ยว
3.ช่วยให้เกสรตัวผู้สมบูรณ์ ทะลายปาล์มใหญ่ ผลดก
ในประเทศไทยการใช้ฮอร์โมนพืชมีวัตถุประสงค์ในทางการเกษตรเพื่อให้มีผลผลิต เพื่อเพิ่มผลผลิตและคุณภาพ และเพื่อความสะดวกในการจัดการฟาร์ม


จุลินทรีย์ด้านอุตสาหกรรมและสิ่งแวดล้อม
ในปัจจุบันนิยมนำจุลินทรีย์มาช่วยรักษาสิ่งแวดล้อมให้สะอาด โดยเฉพาะในโรงงานอุตสาหกรรมที่มีการปนเปื้อนของสารพิษเหล่านี้อยู่ ทั้งที่ปนเปื้อนในแหล่งน้ำและในดิน เช่น การนำจุลินทรีย์มาบำบัดสารมลพิษที่ย่อยสลายยาก ทั้งที่เป็นสารอินทรีย์และสารอนินทรีย์โดยจุลินทรีย์เหล่านี้ จะย่อยสลายสารมลพิษเหล่านี้ให้มีความเป็นพิษน้อยลงหรือย่อยจนสารพิษนั้นหมดไป ทั้งนี้ขึ้นอยู่กับความเป็นพิษของสารนั้นและชนิดของจุลินทรีย์ที่นำมาบำบัด

ตัวอย่างจุลินทรีย์ที่ใช้ในกำจัดของเสีย
ในปัจจุบันมีการพัฒนาทางด้านเทคโนโลยีต่างๆ มากมายก่อให้เกิดสารพิษตกค้างพวกโลหะหนักหรือสาร อินทรีย์ในสิ่งแวดล้อม จุลินทรีย์บางพวกสามารถย่อยสลายหรือทำให้สารพิษเสื่อมสภาพ จึงมีการนำจุลินทรีย์มาย่อยสลายสารอินทรีย์ที่สะสมอยู่โดยเปลี่ยนเป็นก๊าซคาร์บอนไดออกไซด์หรือมีเทน ที่นำไปใช้เป็นพลังงานได้ คราบน้ำมันในทะเลทำให้สิ่งมีชีวิตในน้ำขึ้นมาหายใจไม่ได้ มีแบคทีเรียหลายชนิดสามารถย่อยคราบน้ำมันหรือทำให้คราบน้ำมันแตกออกเป็นหยดเล็กๆจมลงสู่ก้นทะเลได้